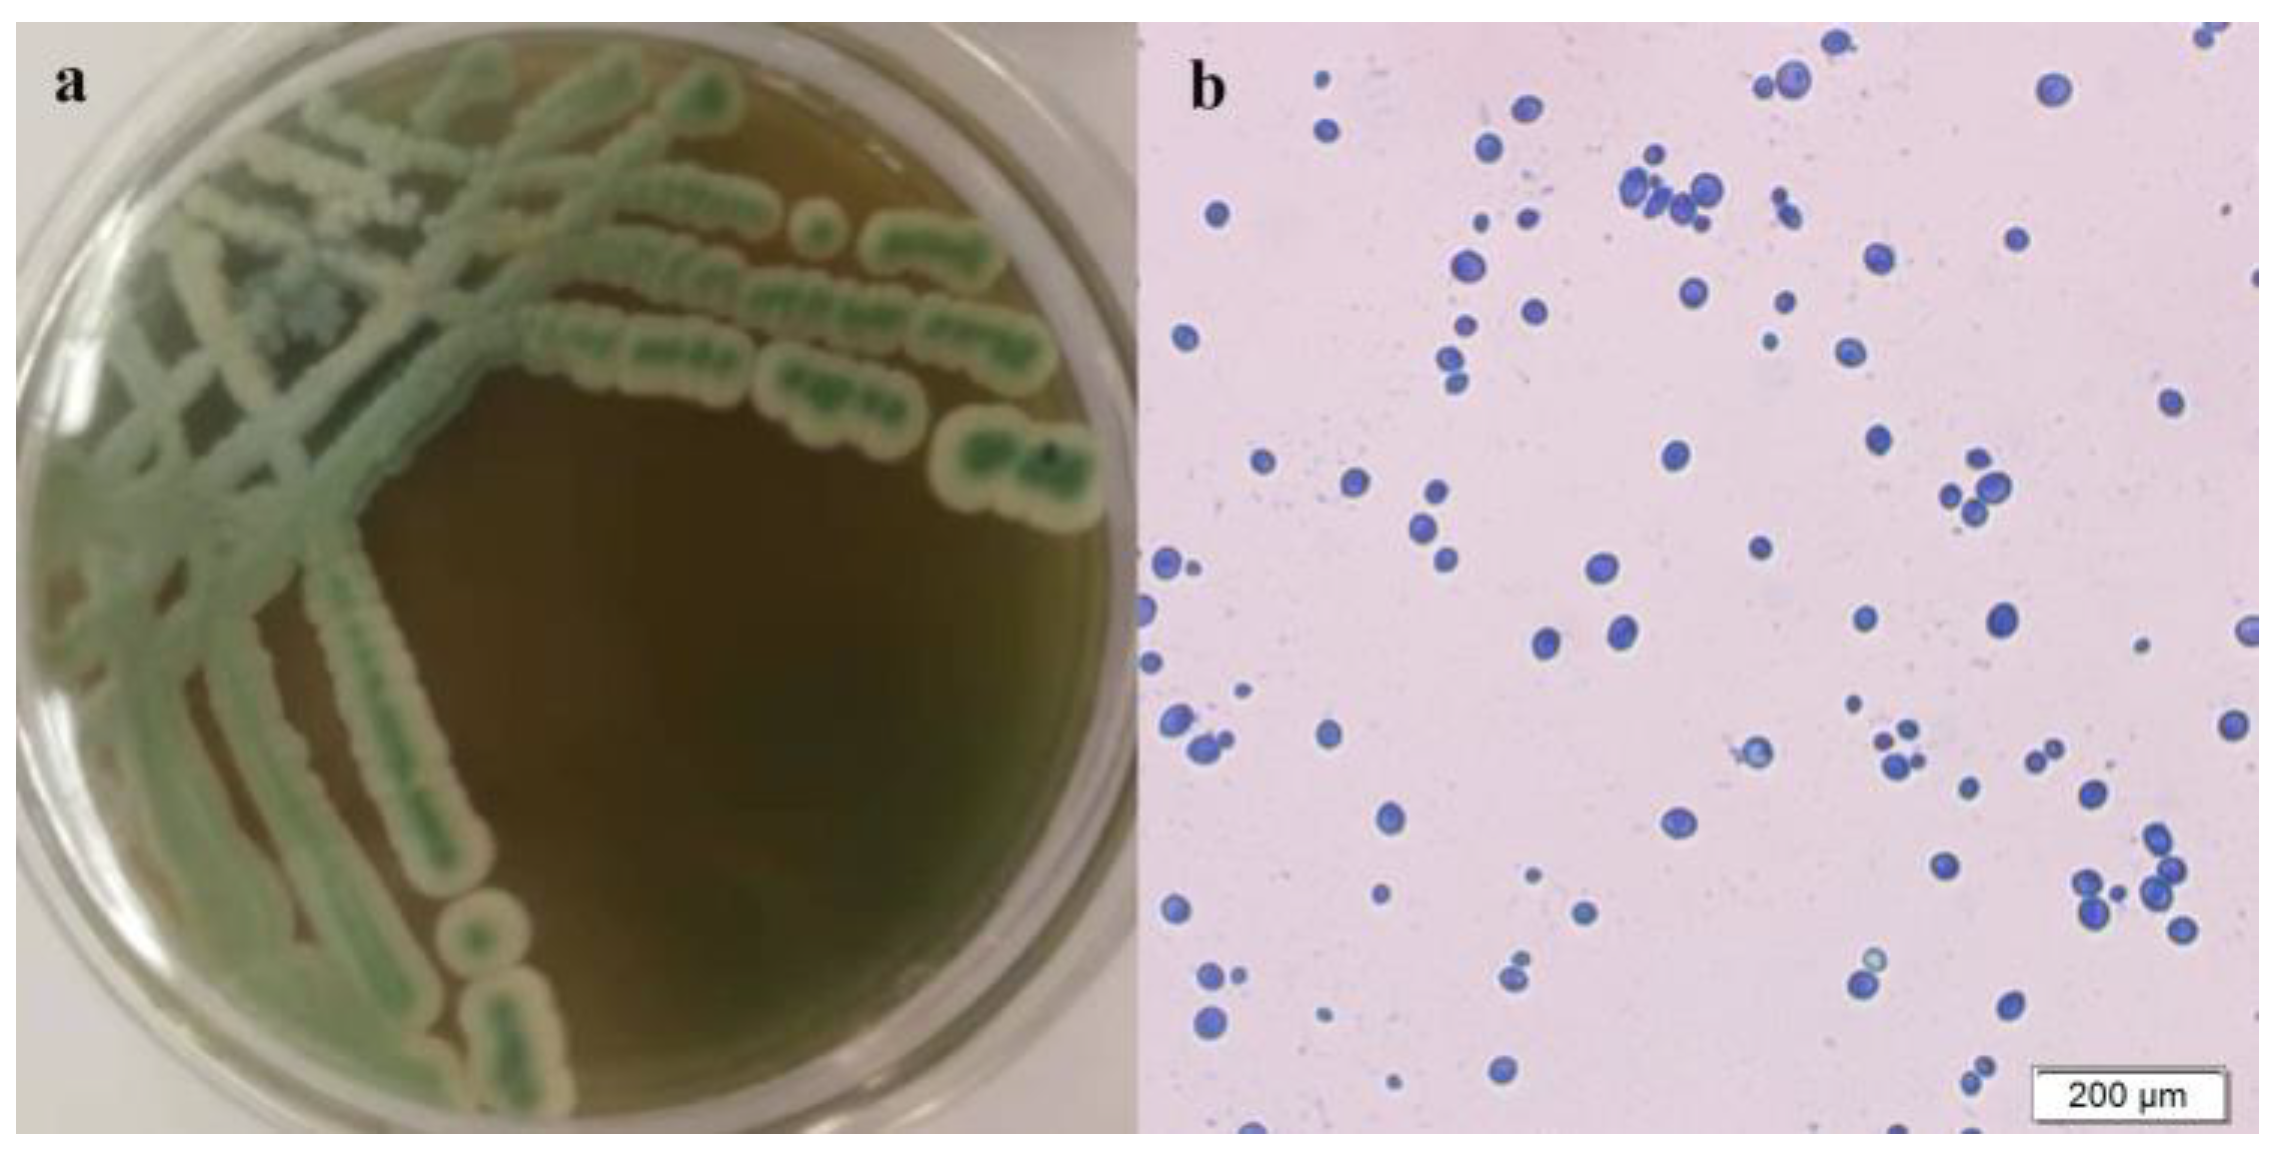
Foods 13 01296 g001

Screening of a Saccharomyces cerevisiae Strain with High 3-Methylthio-1-Propanol Yield and Optimization of Its Fermentation Conditions
Abstract
:1. Introduction
2. Materials and Methods
2.1. Materials
2.2. Medium
2.3. Screening of High-Yielding 3-Met Yeast Strains
2.4. Identification and Performance Testing of Yeast Strains
2.5. Optimization of 3-Met Production by Single-Factor Design (SFD)
2.6. Optimization of 3-Met Production by Plackett–Burman (PB) Test
2.7. Optimization of 3-Met Production by Steepest Ascent Path Design (SAPD)
2.8. Optimization of 3-Met Production by Response Surface Methodology (RSMD)
2.9. Determination of 3-Met Content
2.10. Data Analysis
3. Results and Discussion
3.1. Screening of High-Yielding 3-Met Strain
3.2. Identification and Performance Testing of Strain Y03401
3.3. Optimization of 3-Met Production by SFD
3.3.1. Effect of Medium Components on 3-Met Production by S. cerevisiae Y03401
3.3.2. Effect of Fermentation Conditions on 3-Met Production by S. cerevisiae Y03401
3.4. Optimization of 3-Met Production by PB Test
0.01602 × X6 + 0.00041 × X7 − 0.00503 × X8 + 0.1795 × X9
3.5. Optimization of 3-Met Production by SAPD
3.6. Optimization of 3-Met Production by RSMD
0.0010 × AC − 0.0562 × BC
4. Conclusions
Author Contributions
Funding
Institutional Review Board Statement
Informed Consent Statement
Data Availability Statement
Acknowledgments
Conflicts of Interest
References
- Liu, B.; Wang, X.F.; Zhao, J.H.; Qin, L.H.; Shi, L.; Zhou, T.; Liu, S.; Wang, C.L. Effects of salinity on the synthesis of 3-methylthiopropanol, 2-phenylethanol, and isoamyl acetate in Zygosaccharomyces rouxii and Z. rouxii 3-2. Bioproc. Biosyst. Eng. 2020, 43, 831–838. [Google Scholar] [CrossRef]
- Laurence, G.; Philippe, P.; Aurore, T.; Sonia, C. 3-methylthiopropionaldehyde as precursor of dimethyl trisulfide in aged beers. J. Agric. Food Chem. 2000, 48, 6196–6199. [Google Scholar] [CrossRef]
- Fan, H.Y.; Fan, W.L.; Xu, Y. Characterization of key odorants in Chinese Chixiang aroma-type liquor by gas chromatography-olfactometry, quantitative measurements, aroma recombination, and omission studies. J. Agric. Food Chem. 2015, 63, 3660–3668. [Google Scholar] [CrossRef]
- Park, H.J.; Lee, S.M.; Song, S.H.; Kim, Y.S. Characterization of volatile components in Makgeolli, a traditional Korean rice wine, with or without pasteurization, during storage. Molecules 2013, 18, 5317–5325. [Google Scholar] [CrossRef]
- Jiang, B.; Xi, Z.M.; Luo, M.J.; Zhang, Z.W. Comparison on aroma compounds in Cabernet Sauvignon and Merlot wines from four wine grape-growing regions in China. Food Res. Int. 2013, 51, 482–489. [Google Scholar] [CrossRef]
- Peng, B.Z.; Li, F.L.; Cui, L.; Guo, Y.D. Effects of fermentation temperature on key aroma compounds and sensory properties of apple wine. J. Food Sci. 2015, 80, S2937–S2943. [Google Scholar] [CrossRef]
- Chen, S.; Xu, Y. The influence of yeast strains on the volatile flavour compounds of Chinese rice wine. J. Inst. Brew. 2010, 116, 190–196. [Google Scholar] [CrossRef]
- Fedrizzi, B.; Magno, F.; Badocco, D.; Nicolini, G.; Versini, G. Aging effects and grape variety dependence on the content of sulfur volatiles in wine. J. Agric. Food Chem. 2007, 55, 10880–10887. [Google Scholar] [CrossRef]
- Liu, J.; Wu, Q.; Wang, P.; Lin, J.C.; Huang, L.; Xu, Y. Synergistic effect in core microbiota associated with sulfur metabolism in spontaneous Chinese liquor fermentation. Appl. Environ. Microbiol. 2017, 83, e01475-17. [Google Scholar] [CrossRef]
- Peng, B.Z.; Yue, T.L.; Yuan, Y.H. Analysis of key aroma components in cider from Shaanxi (China) Fuji apple. Int. J. Food Sci. Technol. 2009, 44, 610–615. [Google Scholar] [CrossRef]
- Luo, T. Characteristic Aroma of Light Aroma Style Chinese Rice Wines and Effects of Wheat Qu by GC-O Coupled with GC-MS. Master Thesis, Jiangnan University, Wuxi, China, 2008. [Google Scholar]
- Du, R.B.; Liu, J.; Jiang, J.; Wang, Y.Q.; Ji, X.A.; Yang, N.; Wu, Q.; Xu, Y. Construction of a synthetic microbial community for the biosynthesis of volatile sulfur compound by multi-module division of labor. Food Chem. 2021, 347, 129036. [Google Scholar] [CrossRef]
- Castillo-Lozano, M.L.D.; Spinnler, A.D.H.E.; Bonnarme, P.; Landaud, S. Comparison of volatile sulphur compound production by cheese-ripening yeasts from methionine and methionine–cysteine mixtures. Appl. Microbiol. Biotechnol. 2007, 75, 1447–1454. [Google Scholar] [CrossRef]
- Seow, Y.X.; Ong, P.K.C.; Liu, S.Q. Production of flavour-active methionol from methionine metabolism by yeasts in coconut cream. Int. J. Food Microbiol. 2010, 143, 235–240. [Google Scholar] [CrossRef]
- Buzzini, P.; Romano, S.; Turchetti, B.; Vaughan, A.; Pagnoni, U.M.; Davoli, P. Production of volatile organic sulfur compounds (VOSCs) by basidiomycetous yeasts. FEMS Yeast Res. 2005, 5, 379–385. [Google Scholar] [CrossRef]
- Koh, M.K.P.; Sun, J.C.; Liu, S.Q. Optimization of L-methionine bioconversion to aroma-active methionol by Kluyveromyces lactis using the Taguchi method. J. Food Res. 2013, 2, 90–100. [Google Scholar] [CrossRef]
- Hou, S.; Zhao, L.; Yang, X.L.; Wang, C.T. Study on conditions of bio-transformation of 3-(methylthio)-1-propanol by Saccharomyces cerevisiae SC408. J. Food Sci. Technol. 2011, 29, 18–22. [Google Scholar] [CrossRef]
- Liu, L.; Yin, S.; Liang, J.R.; Wang, C.T.; Zhao, J.X. Cloning of the aminotransferase gene ARO8 and its influence on the production of methionol in Saccharomyces cerevisiae. Sci. Technol. Food Ind. 2014, 35, 132–135. [Google Scholar] [CrossRef]
- Wang, C.T.; Hou, S.; Zhao, L. Application of coupling of reaction and separation technique (CRST) to biocatalytic processes of natural 3-methylthiopropanol. In Proceedings of the 2010 First International Conference on Cellular, Molecular Biology, Biophysics and Bioengineering, Qiqihar, China, 25–26 December 2010; p. 4. [Google Scholar]
- Zhang, Y.J.; Sun, Q.; Liu, X.Y.; Basit, R.A.; Ma, J.H.; Fu, Z.L.; Cheng, L.J.; Fan, G.S.; Teng, C. Screening, identification, and fermentation condition optimization of a high-yield 3-methylthiopropanol yeast and its aroma-producing characteristics. Foods 2024, 13, 418. [Google Scholar] [CrossRef]
- Ma, J.H.; Cheng, L.J.; Zhang, Y.J.; Liu, Y.C.; Sun, Q.; Zhang, J.; Liu, X.Y.; Fan, G.S. Screening of yeasts isolated from Baijiu environments for producing 3-methylthio-1-propanol and optimizing production conditions. Foods 2022, 11, 3616. [Google Scholar] [CrossRef]
- Che, Y.X.; Yin, S.; Wang, H.; Yang, H.Q.; Xu, R.X.; Wang, Q.; Wu, Y.P.; Boutet, J.; Huet, R.; Wang, C.T. Production of methionol from 3-methylthiopropionaldehyde by catalysis of the yeast alcohol dehydrogenase Adh4p. J. Agric. Food Chem. 2020, 68, 4650–4656. [Google Scholar] [CrossRef]
- Yin, S.; Lang, T.D.; Xiao, X.; Liu, L.; Sun, B.G.; Wang, C.T. Significant enhancement of methionol production by co-expression of the aminotransferase gene ARO8 and the decarboxylase gene ARO10 in Saccharomyces cerevisiae. FEMS Microbiol. Lett. 2015, 362, fnu043. [Google Scholar] [CrossRef]
- Deed, R.C.; Hou, R.; Kinzurik, M.I.; Gardner, R.C.; Fedrizzi, B. The role of yeast ARO8, ARO9 and ARO10 genes in the biosynthesis of 3-(methylthio)-1-propanol from L-methionine during fermentation in synthetic grape medium. FEMS Yeast Res. 2019, 19, foy109. [Google Scholar] [CrossRef]
- Etschmann, M.M.W.; Kötter, P.; Hauf, J.; Bluemke, W.; Entian, K.D.; Schrader, J. Production of the aroma chemicals 3-(methylthio)-1-propanol and 3-(methylthio)-propylacetate with yeasts. Appl. Microbiol. Bio. 2008, 80, 579–587. [Google Scholar] [CrossRef]
- Arfi, K.; Tache, R.; Spinnler, H.E.; Bonnarme, P. Dual influence of the carbon source and l-methionine on the synthesis of sulphur compounds in the cheese-ripening yeast Geotrichum candidum. Appl. Microbiol. Bio. 2003, 61, 359–365. [Google Scholar] [CrossRef]
- Buchana, R.E.; Gibbons, N.E. Bergey’s Manual of Determinative Bacteriology, 8th ed.; Science Press: Beijing, China, 1984; pp. 382–533. [Google Scholar]
- Dong, X.Z.; Cai, M.Y. Ommon Bacteria Manual System Identification; Science Press: Beijing, China, 2001; pp. 348–392. [Google Scholar]
- Fan, G.S.; Teng, C.; Xu, D.; Fu, Z.L.; Liu, P.X.; Wu, Q.H.; Yang, R.; Li, X.T. Improving ethyl acetate production in Baijiu manufacture by Wickerhamomyces anomalus and Saccharomyces cerevisiae mixed culture fermentations. BioMed Res. Int. 2019, 2019, 1470543. [Google Scholar] [CrossRef]
- Fan, G.S.; Liu, P.X.; Wu, Q.H.; Fu, Z.L.; Zhu, Y.T.; Cheng, L.J.; Li, X.T. Isolation and identification of a high—Yield ethyl alcohol yeast in aerobic conditions and its biological characteristics. Sci. Technol. Food Ind. 2019, 40, 138–143. [Google Scholar] [CrossRef]
- Wang, X.S.; Wang, B.W.; Sun, Z.G.; Tan, W.; Zheng, J.; Zhu, W.Y. Effects of modernized fermentation on the microbial community succession and ethyl lactate metabolism in Chinese baijiu fermentation. Food Res. Int. 2022, 159, 111566. [Google Scholar] [CrossRef]
- Hong, L.X.; Fu, G.M.; Liu, T.; Chen, Y.R.; Wu, S.W.; Cai, W.Q.; Xie, Z.J.; Wan, Y. Functional microbial agents enhance ethanol contents and regulate the volatile compounds in Chinese Baijiu. Food Biosci. 2021, 44, 101411. [Google Scholar] [CrossRef]
- Fan, G.S.; Xu, D.; Fu, Z.L.; Xu, C.Y.; Teng, C.; Sun, B.G.; Li, X.T. Screen of aroma-producing yeast strains from Gujinggong daqu and analysis of volatile flavor compounds produced by them. J. Chin. Inst. Food Sci. Technol. 2018, 18, 220–229. [Google Scholar] [CrossRef]
- Fan, G.S.; Liu, P.X.; Chang, X.; Yin, H.; Cheng, L.J.; Teng, C.; Gong, Y.; Li, X.T. Isolation and identification of a high-yield ethyl caproate-producing yeast from Daqu and optimization of its fermentation. Front. Microbiol. 2021, 12, 663744. [Google Scholar] [CrossRef]
- Sánchez, S.; Chávez, A.; Forero, A.; García-Huante, Y.; Romero, A.; Sánchez, M.; Rocha, D.; Sánchez, B.; Ávalos, M.; Guzmán-Trampe, S.; et al. Carbon source regulation of antibiotic production. J. Antibiot. 2010, 63, 442–459. [Google Scholar] [CrossRef]
- Perpète, P.; Duthoit, O.; Maeyer, S.D.; Imray, L.; Lawton, A.I.; Stavropoulos, K.E.; Gitonga, V.W.; Hewlins, M.J.E.; Dickinson, J.R. Methionine catabolism in Saccharomyces cerevisiae. FEMS Yeast Res. 2006, 6, 48–56. [Google Scholar] [CrossRef]
- Mouret, J.R.; Perez, M.; Angenieux, M.; Nicolle, P.; Farines, V.; Sablayrolles, J.M. Online-based kinetic analysis of higher alcohol and ester synthesis during winemaking fermentations. Food Bioproc. Technol. 2014, 7, 1235–1245. [Google Scholar] [CrossRef]
- Lwa, H.; Sun, J.C.; Liu, S.Q. Optimization of methionol bioproduction by Saccharomyces cerevisiae using response surface methodology. Ann. Microbiol. 2015, 65, 197–205. [Google Scholar] [CrossRef]
- Liang, Y.; Zhu, L.; Gao, M.J.; Zheng, Z.Y.; Wu, J.R.; Zhan, X.B. Influence of Tween-80 on the production and structure of water-insoluble curdlan from Agrobacterium sp. J. Biol. Macromol. 2018, 106, 611–619. [Google Scholar] [CrossRef]
- Quek, J.M.B.; Seow, Y.X.; Ong, P.K.C.; Liu, S.Q. Formation of volatile sulfur-containing compounds by Saccharomyces cerevisiae in soymilk supplemented with l-methionine. Food Biotechnol. 2011, 25, 292–304. [Google Scholar] [CrossRef]
- Chursov, A.; Kopetzky, S.J.; Bocharov, G.; Frishman, D.; Shneider, A. RNAtips: Analysis of temperature-induced changes of RNA secondary structure. Nucleic Acids Res. 2013, 41, W486–W491. [Google Scholar] [CrossRef]

| Factor | Level/Type | Optimization |
|---|---|---|
| Glucose concentration (g/L) | 10, 20, 30, 40, 50, 60, 70, 80, 90, 100 and 110 | 60–90 |
| Yeast extract concentration (g/L) | 0, 0.4, 0.8, 1.2, 1.6 and 2 | 0.4 |
| L-Met concentration (g/L) | 0, 2, 4, 6, 8 and 10 | 2–4 |
| Surfactant types | Control, Tween-20, Tween-40, Tween-60, Tween-80, Triton-100 and Glycerol | Control |
| Initial pH | 3, 4, 5, 6 and 7 | 4 |
| Temperature (°C) | 22, 26, 30, 34 and 38 | 26 |
| Incubation time (h) | 0, 24, 36, 48, 60 and 72 | 36–60 |
| Inoculum size (%) | 0.2, 0.4, 0.8, 1.6 and 3.2 | 1.6 |
| Shaking speed (rpm) | 50, 100, 150, 200 and 250 | 150–200 |
| Loading volume (mL/250 mL) | 25, 50, 75, 100 and 125 | 50 |
| Test Number | X1 (g/L) | X2 (g/L) | X3 (g/L) | X4 (°C) | X5 | X6 (h) | X7 (rpm) | X8 (mL/250 mL) | X9 (%) | 3-Met Concentration (g/L) |
|---|---|---|---|---|---|---|---|---|---|---|
| 1 | 50 | 0.1 | 4 | 28 | 5 | 24 | 200 | 75 | 0.8 | 0.94 |
| 2 | 60 | 0.4 | 2 | 26 | 4 | 36 | 150 | 50 | 1.6 | 1.73 |
| 3 | 50 | 0.7 | 4 | 28 | 3 | 48 | 200 | 25 | 2.4 | 3.1 |
| 4 | 60 | 0.4 | 2 | 26 | 4 | 36 | 150 | 50 | 1.6 | 1.55 |
| 5 | 70 | 0.1 | 4 | 24 | 3 | 24 | 200 | 75 | 2.4 | 1.19 |
| 6 | 70 | 0.7 | 4 | 24 | 5 | 48 | 100 | 75 | 0.8 | 2.37 |
| 7 | 70 | 0.7 | 0 | 28 | 5 | 24 | 200 | 25 | 0.8 | 1.52 |
| 8 | 50 | 0.1 | 0 | 28 | 5 | 48 | 100 | 75 | 2.4 | 1.02 |
| 9 | 70 | 0.1 | 0 | 24 | 5 | 48 | 200 | 25 | 2.4 | 1.12 |
| 10 | 50 | 0.7 | 4 | 24 | 5 | 24 | 100 | 25 | 2.4 | 2.21 |
| 11 | 50 | 0.7 | 0 | 24 | 3 | 48 | 200 | 75 | 0.8 | 1.51 |
| 12 | 60 | 0.4 | 2 | 26 | 4 | 36 | 150 | 50 | 1.6 | 1.74 |
| 13 | 50 | 0.1 | 0 | 24 | 3 | 24 | 100 | 25 | 0.8 | 0.77 |
| 14 | 70 | 0.1 | 4 | 28 | 3 | 48 | 100 | 25 | 0.8 | 1.30 |
| 15 | 70 | 0.7 | 0 | 28 | 3 | 24 | 100 | 75 | 2.4 | 1.48 |
| Groups | 1 | 2 | 3 | 4 | 5 |
|---|---|---|---|---|---|
| Incubation time (h) | 24 | 36 | 48 | 60 | 72 |
| L-Met concentration (g/L) | 0 | 1 | 2 | 3 | 4 |
| Yeast extract concentration (g/L) | 0.2 | 0.4 | 0.6 | 0.8 | 1 |
| 3-Met concentration (g/L) | 1.08 | 1.78 | 2.37 | 3.29 | 1.03 |
| Test Number | Incubation Time (h) | L-Met Concentration (g/L) | Yeast Extract Concentration (g/L) | 3-Met Concentration (g/L) | |||
|---|---|---|---|---|---|---|---|
| A | Code A | B | Code B | C | Code C | Y | |
| 1 | 60 | 0 | 3 | 0 | 0.8 | 0 | 3.37 |
| 2 | 72 | 1 | 3 | 0 | 0.6 | −1 | 2.24 |
| 3 | 60 | 0 | 3 | 0 | 0.8 | 0 | 3.35 |
| 4 | 72 | 1 | 3 | 0 | 1 | 1 | 2.74 |
| 5 | 60 | 0 | 3 | 0 | 0.8 | 0 | 3.45 |
| 6 | 48 | −1 | 3 | 0 | 0.6 | −1 | 1.46 |
| 7 | 48 | −1 | 1 | −1 | 0.8 | 0 | 1.69 |
| 8 | 60 | 0 | 1 | −1 | 0.6 | −1 | 1.94 |
| 9 | 48 | −1 | 3 | 0 | 1 | 1 | 1.97 |
| 10 | 72 | 1 | 5 | 1 | 0.8 | 0 | 3.02 |
| 11 | 60 | 0 | 3 | 0 | 0.8 | 0 | 3.45 |
| 12 | 72 | 1 | 1 | −1 | 0.8 | 0 | 2.46 |
| 13 | 60 | 0 | 1 | −1 | 1 | 1 | 2.49 |
| 14 | 60 | 0 | 5 | 1 | 0.6 | −1 | 2.54 |
| 15 | 48 | −1 | 5 | 1 | 0.8 | 0 | 2.24 |
| 16 | 60 | 0 | 3 | 0 | 0.8 | 0 | 3.54 |
| 17 | 60 | 0 | 5 | 1 | 1 | 1 | 3.00 |
| Strain | 3-Met Concentration (g/L) | Strain | 3-Met Concentration (g/L) | Strain | 3-Met Concentration (g/L) |
|---|---|---|---|---|---|
| 1021 | 0.78 ± 0.06 | F12502 | 0.31 ± 0.09 | F1918 | 0.37 ± 0.06 |
| 1213 | 0.31 ± 0.11 | F13004 | 0.58 ± 0.04 | F1915 | 0.55 ± 0.07 |
| 1273 | 0.46 ± 0.03 | F13011 | 0.00 ± 0.00 | F2405 | 0.00 ± 0.00 |
| 1344 | 0.21 ± 0.07 | F13017 | 0.00 ± 0.0 | Y03401 | 1.30 ± 0.06 |
| 1701 | 0.51 ± 0.03 | F1504 | 0.77 ± 0.08 | Y1401 | 0.00 ± 0.00 |
| 32704 | 0.57 ± 0.10 | F1701 | 0.21 ± 0.05 | Y1405 | 0.66 ± 0.13 |
| 32708 | 0.48 ± 0.08 | F1702 | 0.00 ± 0.00 | Y1511 | 0.27 ± 0.06 |
| 32714 | 0.43 ± 0.01 | F1904 | 0.36 ± 0.06 | Y1517 | 0.00 ± 0.00 |
| 33197 | 0.59 ± 0.07 | F1905 | 0.00 ± 0.00 | Y2#09 | 0.38 ± 0.02 |
| 33260 | 0.36 ± 0.02 | F1912 | 0.00 ± 0.00 | Y41114 | 0.45 ± 0.06 |
| 33298 | 0.76 ± 0.11 | F1913 | 0.33 ± 0.08 | Y8#01 | 1.10 ± 0.10 |
| 33319 | 0.92 ± 0.06 | F1914 | 0.77 ± 0.11 | Y8#03 | 0.96 ± 0.08 |
| F10404 | 1.21 ± 0.08 | F1916 | 0.52 ± 0.04 | YX3307 | 0.39 ± 0.05 |
| Tests | Substrate Type | Results | Tests | Substrate Type | Results |
|---|---|---|---|---|---|
| Nitrogen source assimilation tests | Urea | + | Sugar fermentation tests | D-Xylose | Gas production, no acid |
| Ammonium sulfate | + | Fructose | Acid and gas production | ||
| Potassium nitrate | + | Glucose | Acid and gas production | ||
| L-Met | + | Maltose | Acid and gas production | ||
| L-Tyrosine | + | Lactose | Gas production, no acid | ||
| Carbon source assimilation tests | Ethanol | + | Sucrose | Acid and gas production | |
| Glycerol | + | Other tests | Hydrogen sulfide test | − | |
| Inulin | + | Indole test | − | ||
| D-Ribose | − | Methyl red test | + | ||
| Tolerance range | Temperature (°C) | 20–40 | Voges–Proskauer test | − | |
| NaCl (%, w/v) | 0–6 | Citrate test | + | ||
| Ethanol (%, v/v) | 0–6 | Urea test | − | ||
| Glucose (%, w/w) | 0–45.9 | Starch hydrolysis test | + | ||
| pH | 2–10 | Gelatin liquidized test | − | ||
| 3-Met (g/L) | 1–12 |
| Code | Variable | Low Level (−1) | High Level (+1) | Effect (EXi) | F Values | p Values | Rank | Significance |
|---|---|---|---|---|---|---|---|---|
| X1 | Glucose concentration (g/L) | 50 | 70 | −0.0491 | 0.45 | 0.532 | 6 | - |
| X2 | Yeast extract concentration (g/L) | 0.1 | 0.7 | 0.4859 | 44.1 | 0.001 | 1 | *** |
| X3 | L-Met concentration (g/L) | 0 | 4 | 0.3081 | 17.72 | 0.008 | 2 | ** |
| X4 | Temperature (°C) | 24 | 28 | 0.0159 | 0.05 | 0.837 | 8 | - |
| X5 | Initial pH | 3 | 5 | −0.0146 | 0.04 | 0.849 | 9 | - |
| X6 | Incubation time (h) | 24 | 48 | 0.1922 | 6.9 | 0.047 | 3 | * |
| X7 | Shaking speed (rpm) | 100 | 200 | 0.0203 | 0.08 | 0.792 | 7 | - |
| X8 | Loading volume (mL/250 mL) | 25 | 75 | −0.1256 | 2.95 | 0.147 | 5 | - |
| X9 | Inoculum size (%) | 0.8 | 3.2 | 0.1436 | 3.85 | 0.107 | 4 | - |
| model | 8.46 | 0.015 | * | |||||
| R2 = 0.9384 | R2Adj = 0.8274 | |||||||
| Source | Sum of Squares | DF | Mean Square | F Values | p Values |
|---|---|---|---|---|---|
| Model | 7.03873 | 9 | 0.78208 | 239.27 | 0.000 |
| A-Yeast extract concentration | 0.02282 | 1 | 0.02282 | 6.98 | 0.033 |
| B-L-Met concentration | 0.34501 | 1 | 0.34501 | 105.55 | 0.000 |
| C-Incubation time | 0.09187 | 1 | 0.09187 | 28.11 | 0.001 |
| AB | 0.00203 | 1 | 0.00203 | 0.62 | 0.457 |
| AC | 0.00003 | 1 | 0.00003 | 0.01 | 0.933 |
| BC | 0.00002 | 1 | 0.00002 | 0.01 | 0.933 |
| A2 | 1.48938 | 1 | 1.48938 | 455.67 | 0.000 |
| B2 | 0.50043 | 1 | 0.50043 | 153.10 | 0.000 |
| C2 | 2.27308 | 1 | 2.27308 | 695.44 | 0.000 |
| Residual | 0.02288 | 7 | 0.00327 | ||
| Lack of Fit | 0.00000 | 3 | 0.00000 | 0.00 | 1.000 |
| Pure Error | 0.02288 | 4 | 0.00572 | ||
| Cor Total | 7.06161 | 16 | |||
| R2 = 0.9968 | R2Adj = 0.9926 | ||||
Disclaimer/Publisher’s Note: The statements, opinions and data contained in all publications are solely those of the individual author(s) and contributor(s) and not of MDPI and/or the editor(s). MDPI and/or the editor(s) disclaim responsibility for any injury to people or property resulting from any ideas, methods, instructions or products referred to in the content. |
© 2024 by the authors. Licensee MDPI, Basel, Switzerland. This article is an open access article distributed under the terms and conditions of the Creative Commons Attribution (CC BY) license (https://creativecommons.org/licenses/by/4.0/).
Share and Cite
Sun, Q.; Ma, J.; Basit, R.A.; Fu, Z.; Liu, X.; Fan, G. Screening of a Saccharomyces cerevisiae Strain with High 3-Methylthio-1-Propanol Yield and Optimization of Its Fermentation Conditions. Foods 2024, 13, 1296. https://doi.org/10.3390/foods13091296
Sun Q, Ma J, Basit RA, Fu Z, Liu X, Fan G. Screening of a Saccharomyces cerevisiae Strain with High 3-Methylthio-1-Propanol Yield and Optimization of Its Fermentation Conditions. Foods. 2024; 13(9):1296. https://doi.org/10.3390/foods13091296
Chicago/Turabian StyleSun, Qi, Jinghao Ma, Rana Abdul Basit, Zhilei Fu, Xiaoyan Liu, and Guangsen Fan. 2024. "Screening of a Saccharomyces cerevisiae Strain with High 3-Methylthio-1-Propanol Yield and Optimization of Its Fermentation Conditions" Foods 13, no. 9: 1296. https://doi.org/10.3390/foods13091296







